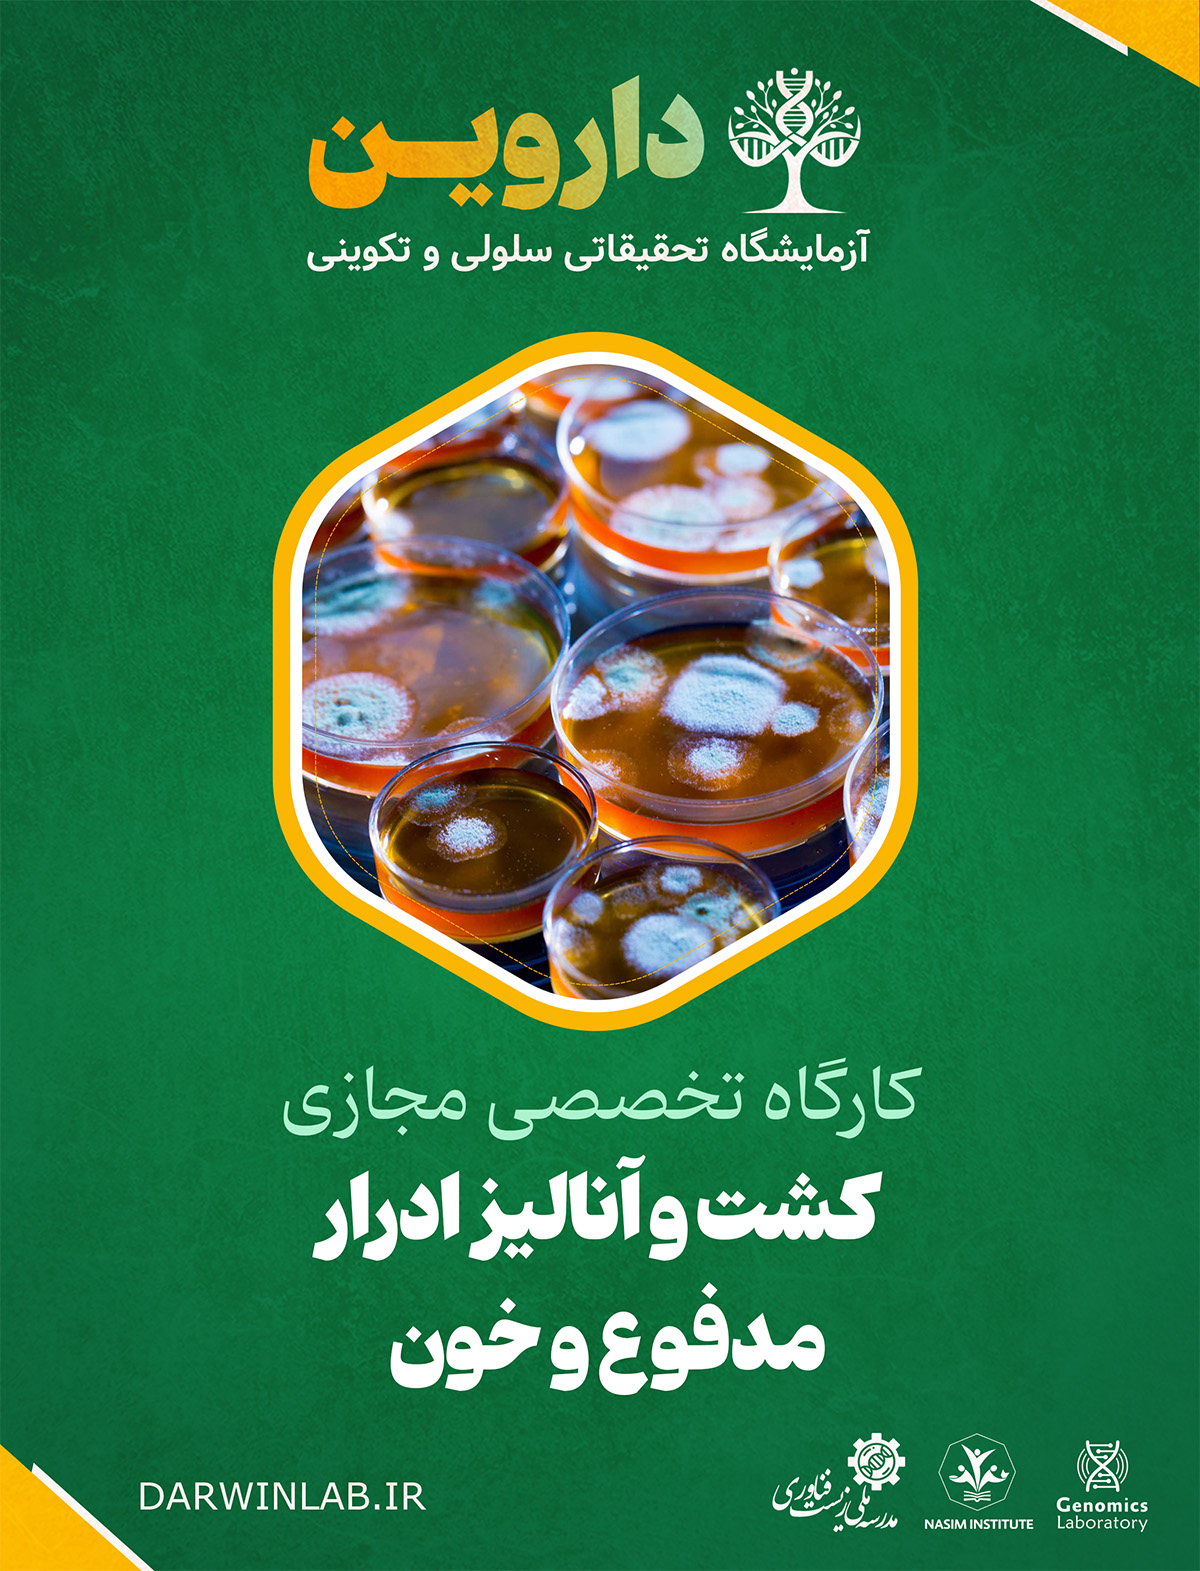
کشت و آنالیز ادرار، مدفوع و خون

آزمایشگاه تحقیقاتی داروین علوم زیستی، جانوری، گیاهی و سلولهای بنیادی
کارگاه کشت و آنالیز ادرار، مدفوع و خون
به دنیای تشخیص آزمایشگاهی، اولین خط دفاع در برابر بیماریهای عفونی خوش آمدید! این کارگاه شما را با اصول عملی و تکنیکهای استاندارد برای کشت و تجزیه و تحلیل نمونههای بالینی کلیدی آشنا میسازد. شما یاد خواهید گرفت که چگونه با دقت و مهارت، سرنخهای میکروبی موجود در نمونهها را ردیابی کرده و نقش مستقیمی در تشخیص بیماری و نجات جان بیماران ایفا کنید.
آنچه در کارگاه کشت و آنالیز ادرار، مدفوع و خون میآموزید:
1. Bacterial Colony Characteristics on Agar Plate (مشخصات کلونی باکتریایی روی پلیت آگار)
در این بخش، شما هنر "خواندن" پلیتهای کشت را فراخواهید گرفت. هر کلونی داستانی برای گفتن دارد:
- شناسایی و تفسیر ویژگیهای مورفولوژیک کلونیها:
- شکل (Form): circular, irregular, filamentous
- حاشیه (Margin): entire, undulate, filamentous
- ارتفاع (Elevation): raised, convex, flat
- سطح (Surface): smooth, rough, wrinkled
- رنگ (Pigmentation): opaque, translucent, تولید رنگدانه (مانند Pseudomonas aeruginosa)
- اندازه (Size) و همولیز (Hemolysis) روی آگار خوندار (Alpha, Beta, Gamma)
- تشخیص اولیه باکتریهای شایع بر اساس ویژگیهای کلونی (مانند کلونی های طلایی Staphylococcus aureus یا کلونی های موکوئیدی Klebsiella pneumoniae).
کاربرد در بازار کار: این مهارت پایهای و حیاتی، اولین قدم در شناسایی پاتوژنها است و برای هر شغلی در آزمایشگاه میکروبیولوژی، از تکنسین تا کارشناس، کاملاً ضروری است. دقت در این مرحله، مسیر تشخیص را به شدت تسریع میکند.
2. Familiarity with Stool Sampling (آشنایی با نمونهبرداری مدفوع)
نمونه مدفوع، گنجینهای از اطلاعات برای تشخیص عفونتهای گوارشی است. در این بخش با اصول صحیح نمونهگیری آشنا میشوید:
- نحوه جمعآوری نمونه در ظرف استریل و جلوگیری از آلودگی با ادرار.
- انواع مختلف آزمایشات بر روی مدفوع: کشت برای پاتوژنهای رودهای (Salmonella, Shigella, Campylobacter)، آزمایش Ova and Parasite (OP) برای انگلها و تست Clostridium difficile.
- شرایط نگهداری و انتقال نمونه (مثلاً برای برخی انگلها باید بلافاصله بررسی شود).
- آمادهسازی اسمیر مستقیم (Direct Smear) برای مشاهده میکروسکوپی.
کاربرد در بازار کار: مهارت در پردازش نمونه مدفوع، شما را برای کار در آزمایشگاههای تشخیص پزشکی، مراکز تحقیقاتی گوارش و همچنین در هنگام شیوع مسمومیتهای غذایی بسیار ارزشمند میکند.
3. Familiarity with the Methods of Sampling (آشنایی با روشهای نمونهبرداری)
این بخش به اصول کلی و حیاتی نمونهبرداری از مایعات بدن میپردازد:
- نمونه ادرار (Urine):
- روش جمعآوری Mid-stream Clean-Catch برای جلوگیری از آلودگی.
- کشت کمی ادرار و تفسیر تعداد کلونی (Colony Forming Unit یا CFU/ml).
- استفاده از محیطهای کشت انتخابی مانند MacConkey Agar و Blood Agar.
- نمونه خون (Blood):
- اصول آسپتیک برای کشت خون (Aseptic Technique) جهت جلوگیری از آلودگی.
- تعداد و زمان نمونهگیری (قبل از شروع آنتیبیوتیک).
- استفاده از بطریهای کشت خون (Blood Culture Bottles) و سیستمهای اتوماتیک.
کاربرد در بازار کار: درک صحیح از روشهای نمونهبرداری، پایه و اساس انجام یک تست قابل اعتماد است. این دانش برای ارتباط موثر با پرسنل نمونهگیر و عیبیابی نتایج غیرعادی کشت ضروری است.
4. Familiarity with CSF Sampling (آشنایی با نمونهبرداری مایع مغزی-نخاعی)
نمونهگیری از مایع مغزی-نخاعی یک روش تهاجمی و بسیار حساس است. در این بخش با حساسیتهای آن آشنا میشوید:
- درک اهمیت نمونه CSF (Cerebrospinal Fluid) در تشخیص مننژیت و انسفالیت.
- نحوه جمعآوری نمونه توسط پزشک از طریق Lumbar Puncture (LP).
- اولویتبندی در پردازش نمونه CSF به دلیل حساسیت بالای آن.
- آمادهسازی و رنگآمیزی گرام (Gram Stain) و کشت روی محیطهای غنی مانند Chocolate Agar.
- تفسیر نتایج کشت و رنگ آمیزی برای پاتوژنهای شایع مانند Neisseria meningitidis, Streptococcus pneumoniae و Haemophilus influenzae.
کاربرد در بازار کار: توانایی کار با نمونههای حساسی مانند CSF، نشاندهنده سطح بالای مهارت و مسئولیتپذیری شما است. این تخصص برای کار در آزمایشگاههای بیمارستانهای تخصصی و مراکز درمانی مجهز، یک امتیاز بزرگ محسوب میشود.
آینده شغلی و بازار کار کشت و آنالیز ادرار، مدفوع و خون:
در سطح بینالملل: تقاضا برای تکنسینهای آزمایشگاه میکروبیولوژی (Microbiology Technologists) همیشه بالا است. فارغالتحصیلان میتوانند در بیمارستانها، کلینیکها، آزمایشگاههای بهداشت عمومی (Public Health Labs) و شرکتهای دارویی فعالیت کنند.
در ایران: با گسترش شبکه آزمایشگاههای تشخیصی و اهمیت روزافزون تشخیص دقیق عفونتها، بازار کار برای تکنسینهای مجرب میکروبیولوژی در ایران بسیار پررونق است. شما میتوانید در:
- آزمایشگاههای پاتولوژی و تشخیص پزشکی سراسر کشور
- بخش میکروبیولوژی بیمارستانهای دولتی و خصوصی
- مراکز تحقیقاتی در زمینه بیماریهای عفونی
- صنایع غذایی و دارویی در بخش کنترل کیفیت میکروبی
قوانین شرکت در کارگاه
محدودیتی در رشته و مقطع تحصیلی شرکت کننندگان وجود ندارد
امکان انصراف از ثبت نام و عودت وجه پرداختی تحت هیچ شرایط امکانپذیر نمی باشد
اجرای کارگاه تنها با استفاده از نرم افزار انلاین استودیو ویژه نسخه ویندوز (8 به بالا) امکان پذیر است
مدت مشاهده محتوای کارگاه از روز شروع 12 روز و غیر قابل تمدید است
جهت دانلود نرم افزار آنلاین استودیو اینجا کلیک نمایید